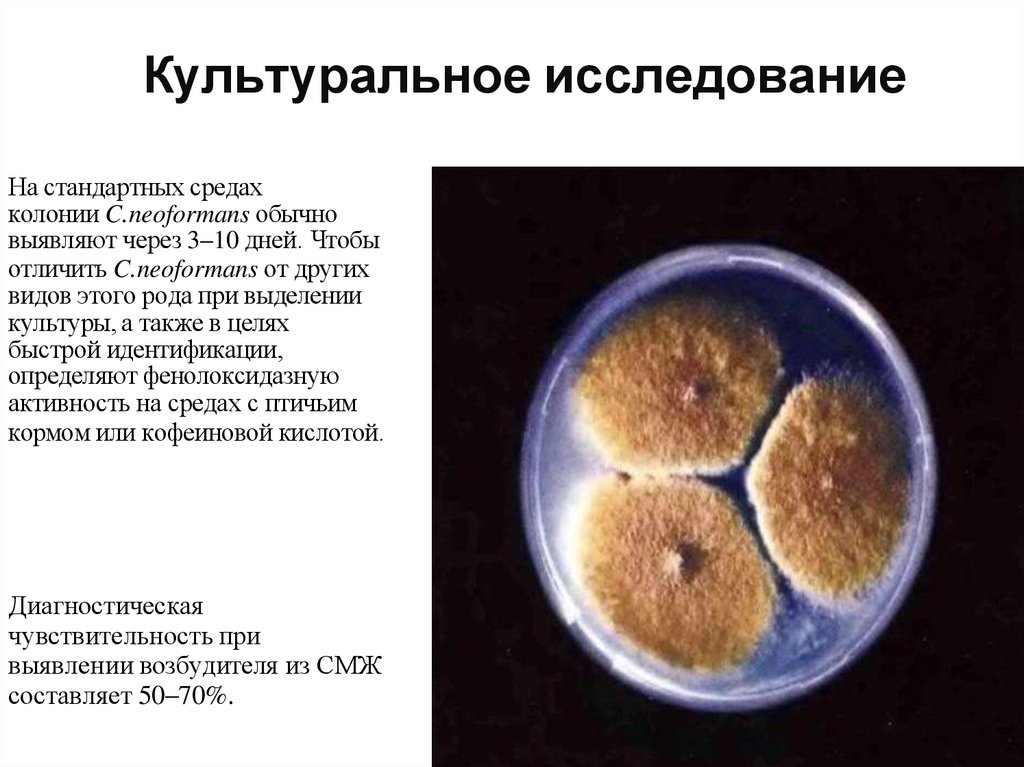

Similar presentations:
Криптококковая инфекция у ВИЧ инфицированных
1.
ГБУЗ «Центр СПИД»Врач КЛД Твердова В.В.
г. Южно-Сахалинск, 2022 г.
2.
3.
Возбудителями криптококкоза у людей являютсягрибки Cryptococcus neoformans и C. gattii.
Морфологическая особенность Cryptococcus
neoformans заключается в том, что это
инкапсулированный гриб. Заболевание, вызванное
данным грибом, называют болезнью Буссе-Бушке, так
как Буссе в 1894 году впервые выделил дрожжевой
гриб, а позже хирург Бушке также сообщил о данном
грибе, выделенном от того же пациента.
Проявляется поражением:
-Нервной системы
-Лёгких
- ЖКТ
-Кожи
-Костей
-Предстательной железы
В настоящее время в США ежегодно
регистрируется около 200 новыхслучаев
заболевания, с летальным исходом в 20-30%
случаев
4.
Существует более 50 видов криптококка,большинство из которых обитает в почве и только
C. neoformans и C. Gattii вызывают заболевание у
людей.
▣ В настоящее время C. neoformans и C. Gattii относят
в двум различным видам криптококка, которые
подразделяются в зависимости от антигенной
специфичности капсулярного полисахарида на 5
серотипов:
▣ C. neoformans – на серотипы A, D и AD.
▣ C. gattii – на серотипы B и C.
▣ Cryptococcus A наиболее часто вызывает развитие
заболевания у иммунодефицитных пациентов,
включая ВИЧ-инфицированных.
▣
5.
6.
Грибы рода Cryptococcus представлены в природе исчитаются космополитами: имеются сообщения
об их выделении на всех материках земного шара,
включая Антарктиду.
▣ Cryptococcus neoformans распространён
повсеместно
▣
C. gattii. только в субтропических областях и связан
в первую очередь с деревьями, особенно с
эвкалиптом.
▣ Во влажном или высушенном голубином помёте
C.neoformans может оставаться жизнеспособным
на протяжении 2 лет и более; обнаруживался в
бродящих фруктовых соках, молоке, масле, траве,
на теле насекомых.
▣
7.
▣▣
▣
▣
▣
▣
C. neoformans вызывает значительное число заболеваний у
иммунодефицитных лиц, включая пациентов с ВИЧ-инфекцией
C. Gattii – у иммунокомпетентных пациентов (70-80% всех случаев
криптококковой инфекции у данной категории больных)
Криптококкоз встречается во всех возрастных группах, но чаще в
возрасте 40-60 лет
Мужчины болеют в 2 раза чаще женщин, расовой или
профессиональной предрасположенности не выявлено
На основании положительных аллергеновых проб с
криптококковым антигеном обнаружено, что 19,8% клинически
«здоровых» людей переболело или сенсибилизировано C.
neoformans
Основной путь передачи – воздушно- пылевой, возможно заражение
через поврежденную кожу или слизистые оболочки
8.
9.
10.
▣ Центральной нервной системы▣ Лёгочная форма
▣ Диссеминированная форма
11.
Криптококкоз ЦНСМенингит (нарушение сознания, рвота)
Криптококкомы (проявляются фокальными неврологическими
дефектами):
-Упорная и выраженная головная боль (часто локализуется в височной или
в лоюной областях)
- головокружение
- раздражительность
- ухудшение памяти
- нарушение сознания (включая изменение личности, ступор, сопор и кому)
12.
▣▣
▣
У иммунокомпетентных лиц клиническая
симптоматика в 54% случаев проявляется кашлем ( в
32% с продукцией незначительного количества мокроты)
и в 46% - плевральной грудной болью. Также
отмечаются субфебрильная температура , общая
слабость, нарушение дыхания,потеря массы телы.
У иммунодефицитных ВИЧ-негативных пациентов
лёгочный криптококкоз протекает быстро, часто с
дессиминацией на ранних сроках. У 83% таких больных
отмечается повышение темепратуры тела и недомогание.
Для ВИЧ-позитивных пациентов с лёгочной формой
криптококкоза также характерны повышение
температуры тела (84%), кашель (63%), диспноэ (50%),
головная боль (41%) и потеря массы тела (47%), при
этом может поражаться любая часть лёгких.
13.
У 10-15% ПАЦИЕНТОВ, ИНФИЦИРОВАННЫХ C. NEOFORMANS,РЕГИСТРИРУЮТСЯ ПОРАЖЕНИЯ КОЖИ.
У ИММУНОКОМПТЕНТНЫХ ЛИЦ КОЖА, КАК ПРАВИЛО, ЯВЛЯЕТСЯ
ЕДИНСТВЕННЫМ ОЧАГОМ ИНФЕКЦИИ.
У ИММУНОДЕФИЦИТНЫХ ЛИЦ, ОСОБЕННО ПРИ СПИДЕ, ПОРАЖЕНИЯ
КОЖИ МОГУТ БЫТЬ ПРИЗНАКАМИ ДИССЕМИНИРОВАННОЙ ФОРМЫ
КРИПТОКОККОЗА.
КОЖНЫЕ ПРОЯВЛЕНИЯ ВСТРЕЧАЮТСЯ В ВИДЕ ПАПУЛ, ПУСТУЛ,
УЗЛОВ, ЯЗВ ИЛИ ДРЕНИРУЮЩИХ СИНУСОВ. У БОЛЬНЫХ В СТАДИИ
СПИДА ПАПУЛЫ С ВДАВЛЕНИЕМ В ЦЕНТРЕ МОГУТ НАПОМИНАТЬ
СЛУЧАИ КОНТАГИОЗНОГО МОЛЛЮСКА.
14.
15.
Визуальное выявление микроорганизма сиспользованием микроскопии
▣ Посев биологического материала с
дальнейшей культуральной и
биохимической идентификацией патогена
▣ Выявление АГ или ДНК C.neoformans
▣
(СМЖ, биоптаты костного мозга, мокрота, моча,
сыворотка/плазма крови, материал из очагов
поражения кожи и др)
▣
Обнаружение АТ к C.neoformans (сыворотка
крови)
16.
ОКРАСКА ПО ГРАМУ, НИГРОЗЗИНОМ ИЛИ ТУШЬЮ ПО БУРРИ,МУЦИКАРМИНОМ ИЛИ КОНГО КРАСНЫМ. КЛЕТКИ КРИПТОКОККОВ
ДИАМЕТРОМ 4–12 МКМ РАСПОЛАГАЮТСЯ ПРЕИМУЩЕСТВЕННО В
МАКРОФАГАХ.
ДИАГНОСТИЧЕСКАЯ ЧУВСТВИТЕЛЬНОСТЬ ИССЛЕДОВАНИЯ СМЖ -40-70%
17.
Культуральное исследованиеНа стандартных средах
колонии C.neoformans обычно
выявляют через 3–10 дней. Чтобы
отличить C.neoformans от других
видов этого рода при выделении
культуры, а также в целях
быстрой идентификации,
определяют фенолоксидазную
активность на средах с птичьим
кормом или кофеиновой кислотой.
Диагностическая
чувствительность при
выявлении возбудителя из СМЖ
составляет 50–70%.
18.
Иммуноферментный методАнтиген C.neoformans в СМЖ удается выявить в 95% случаев при менингите; столь же
демонстративные результаты могут быть получены при сочетании менингита с пневмонией.
- Для выявления АГ применяют метод РА. Ложноположительные результаты определения
возможны при развитии злокачественных новообразований, высоком уровне ревматоидного
фактора в крови, а также при инфекциях, обусловленных Trichosporon spp., Capnocytophaga
canimorsus и Stomatococcus mucilaginosis.
-Для определения специфических АТ к C.neoformans (суммарных или отдельных классов)
применяют методы ИФА. Титры АТ при криптококкозе бывают достаточно высокими — 1:1000
и выше.
У больных на поздних стадиях ВИЧ-инфекции с выраженным иммунодефицитом (СПИД)
определение АТ не всегда бывает эффективным.
19.
Метод ПЦРВыявление специфического фрагмента ДНК C.neoformans позволяет
при однократном тестировании подтвердить клинический диагноз
криптококкоза. Метод ПЦР позволяет выявлять ДНК C.neoformans
var. neoformans и ДНК C.neoformans var.gattii, идентифицировать
штаммы с одинаковой диагностической чувствительностью. Для
мониторинга эффективности проводимой этиотропной терапии
возможно применение ПЦР для определения концентрации ДНК
возбудителя в динамике болезни.

medicine
medicine








